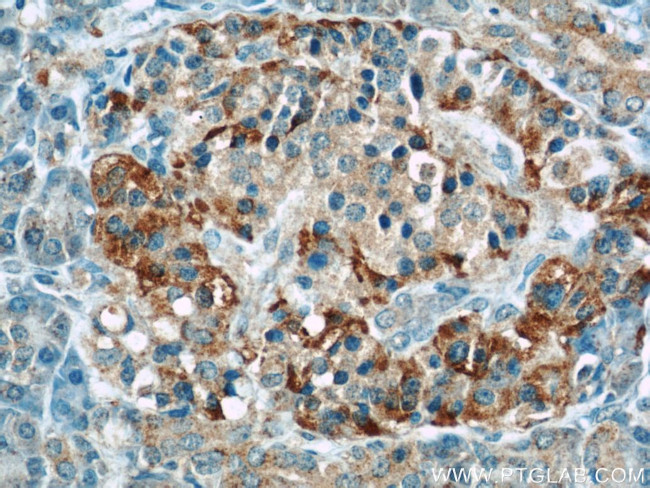
Fibulin 5 Antibody in Immunohistochemistry (Paraffin) (IHC (P))

Search
Proteintech
Fibulin 5 Polyclonal Antibody
{{$productOrderCtrl.translations['antibody.pdp.commerceCard.promotion.promotions']}}
{{$productOrderCtrl.translations['antibody.pdp.commerceCard.promotion.viewpromo']}}
{{$productOrderCtrl.translations['antibody.pdp.commerceCard.promotion.promocode']}}: {{promo.promoCode}} {{promo.promoTitle}} {{promo.promoDescription}}. {{$productOrderCtrl.translations['antibody.pdp.commerceCard.promotion.learnmore']}}












Please note: We are reviewing Western blot images included in the antibody testing data in our catalog, including those provided by third parties. Unless expressly labeled or annotated as “raw-unedited”, Western blot images included in the antibody testing data in our catalog may have been edited, optimized or otherwise adjusted for presentation.
产品信息
12188-1-AP
种属反应
已发表种属
宿主/亚型
分类
类型
抗原
偶联物
形式
浓度
规格
纯化类型
保存液
内含物
保存条件
运输条件
产品详细信息
This antibody got 50 kDa or 66 kDa band in western blotting, the 66 kDa corresponding to fully glycosylated protein.
Immunogen sequence: GSYSCTCNP GFTLNEDGRS CQDVNECATE NPCVQTCVNT YGSFICRCDP GYELEEDGVH CSDMDECSFS EFLCQHECVN QPGTYFCSCP PGYILLDDNR SCQDINECEH RNHTCNLQQT CYNLQGGFKC IDPIRCEEPY LRISDNRCMC PAENPGCRDQ PFTILYRDMD VVSGRSVPAD IFQMQATTRY PGAYYIFQIK SGNEGREFYM RQTGPISATL VMTRPIKGPR EIQLDLEMIT VNTVINFRGS SVIRLRIYVS QYPF (186-448 aa encoded by B C022280)
靶标信息
Essential for elastic fiber formation, is involved in the assembly of continuous elastin (ELN) polymer and promotes the interaction of microfibrils and ELN. Stabilizes and organizes elastic fibers in the skin, lung and vasculature. Promotes adhesion of endothelial cells through interaction of integrins and the RGD motif. Vascular ligand for integrin receptors which may play a role in vascular development and remodeling.
仅用于科研。不用于诊断过程。未经明确授权不得转售。
生物信息学
蛋白别名: Dance; Developmental arteries and neural crest EGF-like protein; Embryonic vascular EGF repeat-containing protein; EVEC; FIBL-5; Fibulin-5; FLJ90059
基因别名: A55; DANCE; EVEC; Fbln5
UniProt ID: (Rat) Q9WVH8, (Mouse) Q9WVH9
Entrez Gene ID: (Rat) 29158, (Mouse) 23876